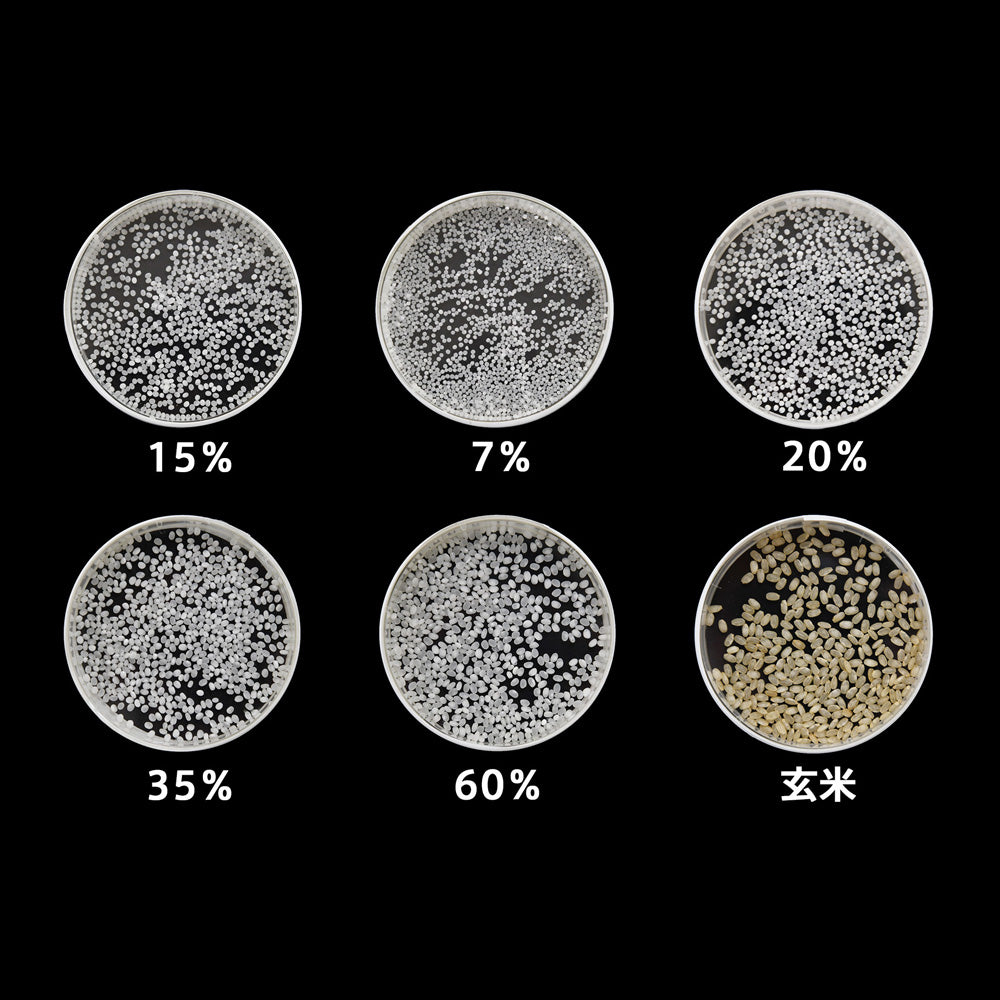
純米大吟醸「楽聖」一割五分磨き

1
/
の
6
D3-MSS9055
純米大吟醸「楽聖」一割五分磨き
純米大吟醸「楽聖」一割五分磨き
通常価格
¥55,000(税込)
通常価格
セール価格
¥55,000(税込)
単価
/
あたり
税込
550
Pontaポイント
受取状況を読み込めませんでした
■商品内容:純米大吟醸「楽聖」一割五分磨き720ml 15.5度
■岡山特産の雄町米を使用した純米大吟醸。花のようなフルーツのみのような香りと、雄町米特有のふくよかな旨味が特徴です。
■宮下酒造は日本酒 地ビール 焼酎 梅酒など様々な酒類を製造・販売する岡山の総合酒類メーカーです。 100年以上の歴史があり、日本酒は「極聖」、地ビールは「独歩」が代表銘柄です。
詳細を表示する
■岡山特産の雄町米を使用した純米大吟醸。花のようなフルーツのみのような香りと、雄町米特有のふくよかな旨味が特徴です。
■宮下酒造は日本酒 地ビール 焼酎 梅酒など様々な酒類を製造・販売する岡山の総合酒類メーカーです。 100年以上の歴史があり、日本酒は「極聖」、地ビールは「独歩」が代表銘柄です。
【オンラインギフトの有効期限】
発行日より90日
年齢確認この商品の購入いただけるのは
20歳以上からです